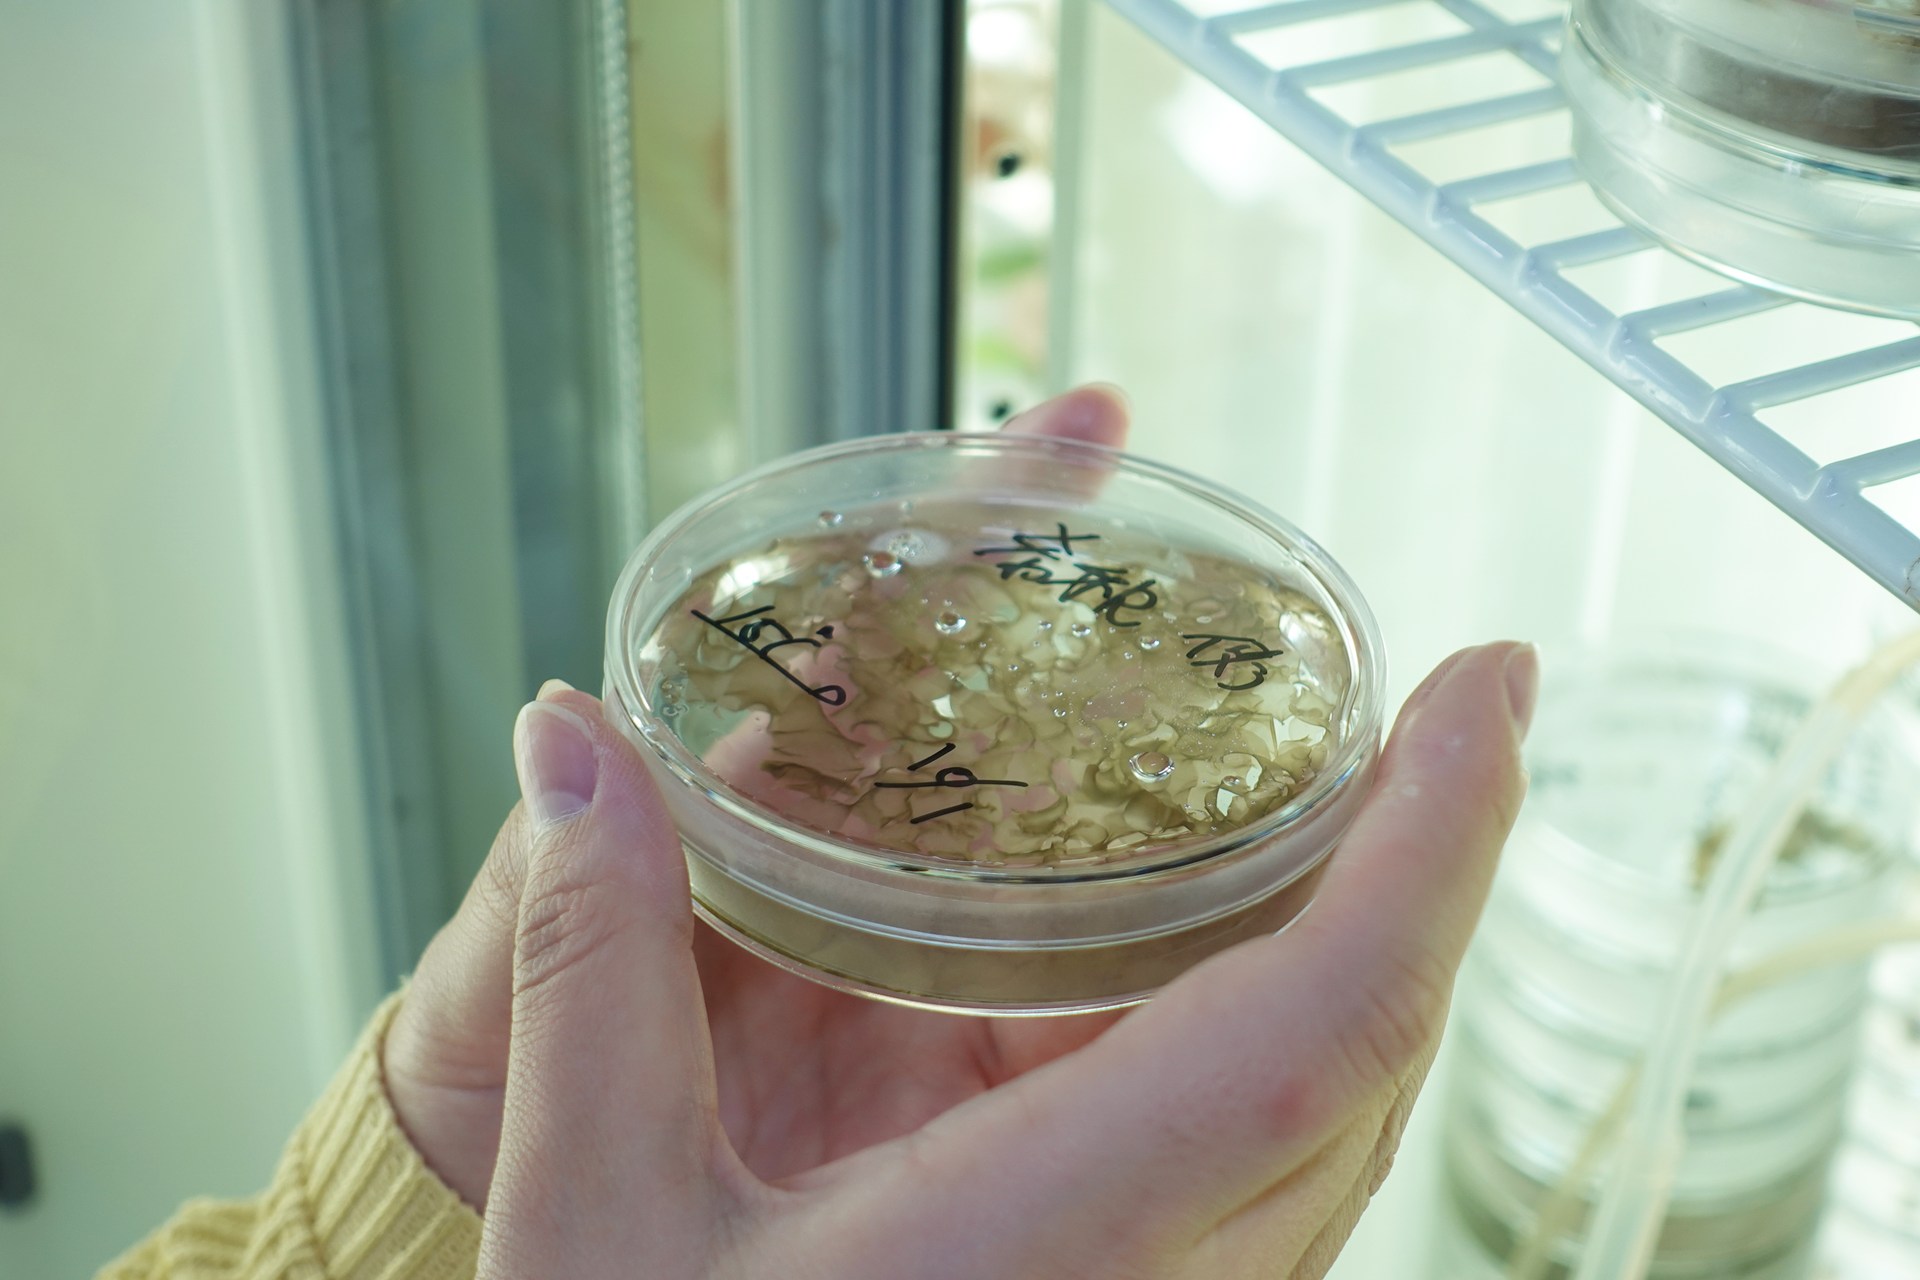

新着情報
25.10.29
食産業学群 佐々木菜瑠さんが日本応用藻類学会の学生優秀賞を受賞/水圏資源植物科学研究室
食産業学群 三上浩司 研究室(水圏資源植物科学研究室)に所属する4年生 佐々木菜瑠さんが、2025年9月13日~14日に熊本県立大学にて開催された日本応用藻類学会第23回大会において、学生優秀賞を受賞しました。佐々木さんは、宮城県気仙沼市岩井崎(三陸復興国立公園)に自生するアマノリ類の季節的消長について研究を行っています。その過程で、系統分類学的な所属が不明のままになっているアマノリを見出し、葉緑体やミトコンドリアのゲノムにコードされている遺伝子の配列解析を初めて行うことで、その系統分類学的な所属を明らかとし、アマノリ類の系統分類学に残されている大きな問題の1つを解決しました。学会では、「宮城県岩井崎産ムロネアマノリの系統分類学的な所属の解明」というタイトルで、その成果を発表しました。
<参考>スサビノリについて:宮城の持続的なノリ養殖のために/食産業学群三上研究室の挑戦

アマノリ類の属再編に基づく「原始紅藻ムロネアマノリの系統分類学的な所属」について
海苔の原材料として知られているスサビノリなどの葉状の形態を示す原始紅藻は、アマノリ類と分類されます。原始紅藻類は、長い間糸状のウシケノリ属(Bangia)と葉状のアマノリ属(Porphyra)の2属に分類されていましたが、2011年にSutherlandらによって、特定の遺伝子配列の比較に基づく分子系統分類法によって大幅な見直しが行われました。その結果、これまで1属だった葉状のアマノリ類が8属に分類され、スサビノリをはじめとする日本産のアマノリはPyropia属に再編されました。そのため、スサビノリの学名は、Porphyra yezoensisからPyropia yezoensisに変更となっています。


このような属の再編に置き去りにされたアマノリ類がありますが、これらは希少種あるいは絶滅種であるため採集が困難であり、遺伝子解析が未だに行われておらず、本来所属する属が不明なことから属名はPorphyraのままとなっています。その中にムロネアマノリが含まれており、学名は現在Porphyra akasakaeが使用されています。そのため、ムロネアマノリが所属する属の解明は、日本産アマノリ類の系統分類における大きな課題となっています。佐々木さんは、その解明を試みました。
宮城県気仙沼市岩井崎におけるアマノリ採集
アマノリ類は冬の寒い時期に出現します。そのため、気仙沼市岩井崎をフィールドとする調査を10月から5月にかけて毎月1回行いました。季節的な消長を明らかにするためには、採集物を同定する必要があります。その場合、葉緑体ゲノムにコードされているルビスコ・ラージサブユニット遺伝子(rbcL)の塩基配列の比較が重要となります。岩井崎では、2月と3月がアマノリの最盛期でしたが、ちょうどそのころに採集したものの中に、これまで報告されていないrbcLの塩基配列を持つアマノリを見つけました(右下図)。このような場合は、新種か過去に遺伝子解析されていないアマノリの発見ということになります。今回採収されたアマノリは、過去に報告があるムロネアマノリに形態的に似ていたことから、後者の可能性が考えられました。

奥の岩場が採集地点(2025年5月30日)

未同定アマノリの標本(2025年3月15日採集)
ムロネアマノリの同定
アマノリ類の有性生殖において、雌性配偶子が持つ受精毛は、雄性配偶子との受精に重要な役割を果たしています。ムロネアマノリの雌性配偶子に見られる受精毛は、他のアマノリ類に比べると極めて短いことが分類形質となっています。そこで今回岩井崎で採集したアマノリの受精毛を観察したところ、図に示すようにスサビノリのものに比べて短いことが判明しました。また、葉状体は、すでに報告があるように雌雄異株でした。これらの形態的な特徴から、新規のrbcL配列を持つアマノリをムロネアマノリと同定しました。

ムロネアマノリの受精毛

スサビノリの受精毛
未解明だったムロネアマノリの系統分類学的な所属の解明
次にムロネアマノリの系統分類学的な所属の解明を試みました。通常アマノリ類の分子系統分類は、rbcLの塩基配列の比較に基づく系統樹解析で行われます。そのためすでに解明したムロネアマノリのrbcL配列を用いて系統樹を作成しましたが、精度が低いものになってしまいました。そこで、ミトコンドリアゲノムのtrnC-rns 領域とATP6 領域の塩基配列を解読して組み合わせて用いたところ、図のような系統樹を作成することができました。その結果、ムロネアマノリがPyropia 属に所属することが判明し、その学名をPorphyra akasakaeからPyropia akasakaeに変更する必要性があることを示すことができました。

分子系統樹解析(ML法)によるムロネアマノリの系統分類学的な所属の解明
佐々木さんはアマノリ類の系統分類学上の問題を解決する大変重要な成果をあげ、日本応用藻類学会の大会では、これに加えていくつかの新規知見を合わせて、多くの大学院生がいる中で唯一の学群4年生として発表し、名誉ある学生優秀賞を受賞しました。

海苔は日本人の食生活に密着していますが、その生産は近年の地球温暖化に伴う海水温の上昇により生産量の減少や品質の低下が顕著となっており、ノリの大規模養殖の北限である宮城県でも例外ではありません。その解消に向けた試みとして、人為的な高温耐性株の作出と自生するアマノリ類からの高温耐性種の選抜の2つがあげられますが、今回受賞した佐々木さんの研究は、後者につながるものです。今後は、岩井崎に自生するアマノリ類の同定に基づく季節的消長の解明と見いだされた各種アマノリの高温耐性能を比較することで高温耐性種が選抜できると期待されます。

受賞学生-佐々木菜瑠さんのコメント
今回の名誉ある受賞は思ってもみなかったことでした。とても嬉しく、これから実験を進めていく上で大きな励みとなります。今後もノリ養殖の持続化に貢献できる高温耐性種の選抜を実現できるように研究を続けていきたいです。これまでお世話になった皆様に感謝いたします。
日本応用藻類学会学生優秀賞
日本応用藻類学会は、応用藻類学の進歩、ならびに、会員相互の情報交換の推進を目的とする学会です。学生優秀賞は2021年に設置され、その後毎年1名の受賞者が選出されていますが、その第1回目の受賞者は、三上研究室に所属していた佐藤夏海さんでした(2021年第19回大会)。今年度の第23回大会でも多くの学生会員の発表がある中で、厳正な審査の結果、栄えある受賞者として佐々木菜瑠さんが選出されました。三上研究室からは2人目の受賞者となります。会長を務める三上浩司教授からは、「宮城大学の学生が再び栄誉ある賞を受賞したことをとても喜ばしく思っております。大会会場で多くの参加者がいる中、卒業研究を指導している佐々木さんに直接賞状授与をできたことは、大変誇らしいことでした。」とのコメントがありました。
指導教員プロフィール
・三上 浩司:食産業学群 教授
植物分子生物学、水圏植物生理学、海藻生物学を専門分野とし、海苔の原材料であるスサビノリやウップルイノリなどの原始紅藻を研究材料として、発生・形態形成・環境ストレス応答などの基礎研究や、それらの知見を活かして、例えば地球温暖化のノリ養殖業へのダメージを緩和するための技術開発や高温耐性品種の作出などの応用研究を行っています。また、日本応用藻類学会の会長を務め食産業学群に学会本部を設置するなど、宮城県を中心とした「東北から世界に向けた海藻研究成果の情報発信」にも取り組んでいます。

<関連>
- 食産業学群三上教授らが紅藻スサビノリにおける高温ストレス応答の研究論文を発表、Feature Paper に選出/生物生産学類
- 食産業学群三上教授らが紅藻スサビノリにおける植物ホルモン・オーキシンの生理作用を化学生物学的に初めて解明:国際学術雑誌「Cells」Feature Paper に選出/生物生産学類
- 食産業学群・三上教授が監修した「かがくのとも2023年1月号『のり』」が福音館書店より発売中
- 食産業学群 佐藤 夏海さんが日本応用藻類学会の学生優秀賞を受賞/水圏資源植物科学研究室
- 国立研究開発法人水産研究・教育機構と公立大学法人宮城大学との包括連携協力に関する協定を締結しました
- 宮城の持続的なノリ養殖のために/食産業学群三上研究室の挑戦
- 海藻の生き様を解明し応用することで宮城県産海苔のトップブランド化を目指します(シーズ集)

